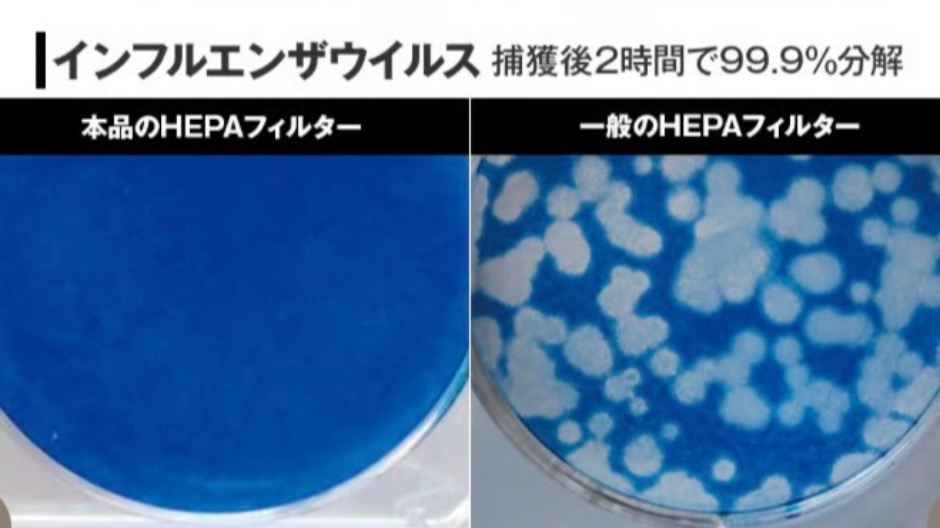

花粉やホコリで毎日くしゃみが止まらない



赤ちゃんのいる部屋の空気が心配…
そんなお悩みはありませんか?
病院や介護施設でも採用されている通販生活の空気清浄機「アースプラス」なら、家庭でも手軽にプロ並みの空気対策ができます。
この記事では、
- アースプラスの価格や特徴
- なぜ花粉症やウイルス対策に効果的なのか
をご紹介します。
この記事を読めば、価格以上の価値があり家族の健康を守る空気清浄機だと分かります。
\ 通販生活公式サイト /
通販生活の空気清浄機「アースプラス」の価格と基本スペック
| 本体価格(税込) | 38,550円(税込) |
|---|---|
| 適用床面積 | 18畳以内 |
| 本体サイズ | 幅37×奥行18.5×高さ48.5cm・コードの長さ1.8m |
| 重量 | 約5.4k |
| 消費電力 | 3.5W(静音)~41W 電気代目安0.28円/時 |
| 製造国 | 日本 |
| 特徴的機能 | アースプラスHEPAフィルター(抗ウイルス・抗菌)搭載 |
| 保証期間 | 5年間無料修理 |
| 販売元 | 株式会社カタログハウス |
| 再生素材使用率 | 本体樹脂の61%に再生プラスチック採用 |
適用床面積は18畳まで対応できるので、リビングダイニングなど家族が集まる部屋でも1台でしっかり空気を清浄できます。
本体サイズはコンパクトで設置場所に困りにくく、5.4kgと比較的軽量なので必要に応じて別の部屋へ移動させることも可能。
例えば、
- 日中はリビング
- 夜間は寝室
という使い方も無理なくこなせます。
価格は38,550円(税込)ですが、5年間の保証期間があります。
5年間という手厚い保証は、長く安心して使い続けることができます。
\ 通販生活公式サイト /
アースプラスのHEPAフィルターがウイルスを99.9%分解!
通販生活の空気清浄機アースプラスが他社製品と最も違う点は、搭載された独自の抗ウイルス素材フィルターにあります。
アースプラスフィルターの仕組みと効果を3つのポイント
- 抗菌素材「アースプラス」
- ウイルス分解性能
- 花粉・ニオイへの効果
に分けてそれぞれ詳しく解説します。
抗菌素材「アースプラス」とは
抗菌素材アースプラスとは
信州セラミックスが開発したセラミックスの複合機能材料です。(酸化チタン、ハイドロキシアパタイト、銀)食品添加物に認可されている成分で構成され、細菌・ウイルス・アレルゲン・臭い(細菌由来)等のタンパク質を吸着分解する技術です。その効果は、医学系英文誌で発表され、国際的に高い評価を受けています。
株式会社信州セラミックス公式サイトより
このアースプラス素材を蜜(みつ)のようにフィルター表面に塗布したものが、通称「トリモチフィルター」と呼ばれるHEPAフィルターです。
アースプラス本体に吸い込まれたウイルス・細菌・花粉などの粒子は、このトリモチフィルターにしっかりキャッチされ、フィルター内の酸化チタンに触れるとタンパク質が分解され始めます。
そして銀イオンが作用してその分解をどんどん促進し、フィルターに捕らえられた有害物質は次々と無害化されていくというメカニズムです。


ポイントは、
フィルターに付着したウイルスが繁殖したり生き残ったりしない
点。
一般的な空気清浄機でも、高性能なHEPAフィルターであればウイルスやPM2.5を捕集できますが、
一方アースプラスは、
ことができます。
99.9%ウイルス分解の実力
信州セラミックスおよび第三者機関の試験結果によれば、アースプラスのHEPAフィルターは,
されています。
実験用の豚コロナウイルスとインフルエンザウイルスをフィルターに付着させたところ、2時間後にはウイルスが99.9%分解されました。

ほぼウイルスを殲滅(せんめつ)すると言ってよいレベル。
また粘着性のコーティングがHEPAフィルターの網目の隙間を埋めるように作用するため、
します。
アースプラスは、ウイルス対策においてトップクラスの性能を備えていると言えます。
花粉・ニオイにも効果的
アースプラス空気清浄機は、ウイルスや菌だけでなく花粉やニオイに対しても効果を発揮します。
花粉
スギ花粉アレルゲンの分解テストでは、未加工の通常HEPAフィルターが30.3%のアレルゲン低減に留まったのに対し、アースプラス加工HEPAフィルターは、
という結果が得られました。


花粉症の原因物質「アレルゲン」の大部分を無害化できるということです。
花粉自体はウイルスより大きい粒子なので、物理的には容易にフィルターで捕集できますが、アレルギー症状を引き起こす物質「アレルゲン」は非常に小さい場合があります。
アースプラスフィルターなら、花粉を吸着してからそのアレルゲンまで分解してくれるので、花粉症の方にとって大きな助けとなります。
ニオイ(脱臭)
アースプラスにはHEPAフィルターに加えて、特殊複合活性炭フィルターも搭載されています。
信州セラミックス独自配合の活性炭により、アンモニアやホルムアルデヒドなど生活臭・化学物質臭を素早く除去できる性能を持っています。
介護の現場ではオムツ臭や生活臭が気になることがありますが、そうしたニオイ成分を即座に吸着してくれるため、空間を快適に保つのに役立ちます。
家庭でもペットのニオイや料理臭、部屋のこもった空気臭などが気になることがありますが、これらにも強力な脱臭効果を発揮してくれます。



我が家では要介護5の義母を在宅介護していました。アースプラスを使うようになってからは介護部屋の嫌な臭いが一気になくなりました。
花粉症・アレルギー・赤ちゃんにも安心な理由
アースプラス空気清浄機は、ウイルスや花粉を分解する優れた性能があります。
この章では、
- 花粉症やアレルギーを持つ方
- 免疫力の弱い赤ちゃん
- 高齢者
にとってどんなメリットがあるのかを解説します。
花粉アレルゲンをしっかり分解
花粉症の方にとって、春先のスギ花粉や秋のブタクサ花粉のシーズンは憂鬱なもの。
室内に入っても花粉が舞い込んできて、



鼻水や目のかゆみが治まらない…
という経験をお持ちの方も多いと思います。
アースプラスは、そうした花粉症シーズンの室内環境改善に大きな威力を発揮します。
前述の通り、アースプラスフィルターはスギ花粉のアレルゲンを3時間で93.3%も低減できる試験結果が出ています。
花粉症だけでなくダニやカビによるアレルギーを持つ方にとっても、室内の花粉症の原因物質「アレルゲン」の総量を減らせるので、
です。
赤ちゃんや高齢者にも安全
アースプラスは、この2点
- 有害な副産物を出さない
- 空気感染から守る効果
の理由から、小さなお子さんや高齢の方がいるご家庭にも安心して使える設計となっています。
有害な副産物を出さない
最近の空気清浄機には、プラズマクラスターやナノイー、オゾン発生など様々な空気改善技術が搭載されることがありますが、場合によっては微量ながらオゾンや化学物質を放出するものもあります。
しかしアースプラスはシンプルにフィルターで空気を浄化する方式であり、オゾンやイオンによる副作用の心配がありません。
フィルターに使われているアースプラス素材も、前述の通り極めて安全性が高い成分で、食品添加物レベルの安全基準を満たしています。
毒性が極めて低く、フィルターから何かが溶け出すこともないため、赤ちゃんがいる部屋でも安心して24時間稼働させておけます。
空気感染から守る効果
新生児や乳児、あるいは高齢者は抵抗力が弱く、インフルエンザやRSウイルスなどに感染すると重症化しやすいリスクがあります。
空気中のウイルスは見えない脅威ですが、アースプラス空気清浄機があれば、そうしたウイルスを捕まえて分解し室内感染のリスクを下げることができます。
特に冬場など窓を閉め切りがちな季節でも、空気清浄機を回しておけば常に空気を循環&浄化し続けてくれるので安心感が違います。



換気しづらいけどウイルスは心配…
というご家庭には強い味方になります。
静音モードで夜も快適


小さなお子さんがいる家庭や、就寝時にも空気清浄機を動かしたい方にとって、運転音の静かさは重要なポイントです。
アースプラスは静音運転時の音がとても静かで、夜間でも快適に使用できます。
実際に静音モードを使用した感覚では、運転音はサーッという微かな空調音程度で、寝室で稼働させても赤ちゃんの眠りを邪魔しないレベルでした。
これなら一晩中つけておいても問題ないと思います。
夜寝ている間も空気清浄機を回しておけば、花粉やホコリを常に除去し続けてくれるので、翌朝の目覚めが違います。



夜は音が気になるから空気清浄機を止めている
という方には、アースプラスの静かさは大きなメリットの1つです。
購入方法
アースプラスは通販生活限定で販売されています。
一般の家電量販店やAmazonなどの大手ECサイトでは扱っていません(もし出品があっても転売や中古の可能性があります)。
確実に正規の新品を購入するには、
- 公式ウェブサイト
- 電話
- ハガキ
- FAX
で申し込む形になります。
公式サイトでは在庫状況や納期の目安も確認できます。
支払い方法もクレジットカードから代引きまで選べて便利です。
\ 通販生活公式サイト /
まとめ
通販生活の空気清浄機「アースプラス」は、一言でいえば
です。
税込約38,550円という価格は、一般的な空気清浄機より高めかもしれませんが、価格に見合うだけの優れた機能と実績があります。
- ウイルスや細菌を99.9%分解するフィルター性能
特許技術アースプラス™を塗布したHEPAフィルターがウイルス・菌・花粉を強力に吸着・無力化。家庭内の空気感染リスクや花粉・アレルギー物質を大幅に低減してくれます。 - 花粉症やアレルギー持ちに嬉しい効果
花粉アレルゲンを約93.3%も低減し、PM2.5やホコリもしっかりキャッチ。赤ちゃんや高齢者がいる環境でも安心して使える安全設計で、副産物も出さず静音運転も優秀。 - 医療現場お墨付きの信頼性
全国の病院・施設で多数採用されてきた実績があり、品質は折り紙付き。エコマーク認定取得や国内生産による丁寧な作りも信頼性を高めています。5年保証付きでアフターサービスも万全。 - 維持費は低めでお手入れ簡単
フィルター寿命が長く(静音モード約2年半)交換は数年に一度、電気代も1日あたり数円レベルと経済的で、日常の手間はほとんどかかりません。
以上のように、価格以上の価値がこの1台に凝縮されています。
- 花粉症で辛い思いをしている方
- 室内のウイルス対策に不安がある方
- 小さなお子さんや高齢
の家族を少しでも衛生的な環境で過ごさせたい方には、アースプラスは、頼もしい相棒になってくれること間違いなし。
実際に使ってみると、



なるほど、これは高くても導入する価値があった!
と、きっと感じられるはずです。
\ 通販生活公式サイト /








